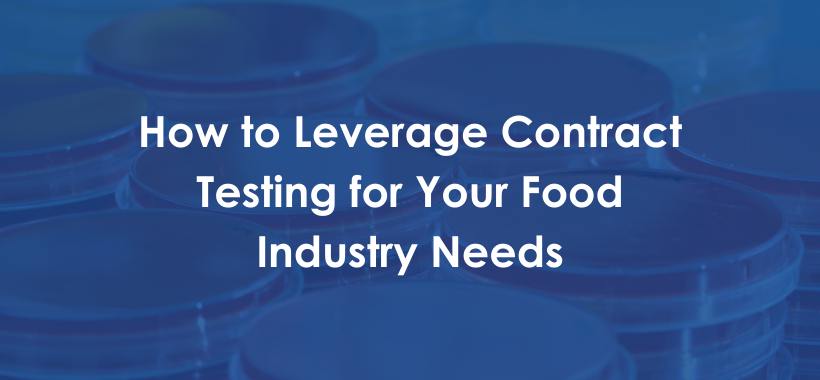

As a food testing laboratory manager, managing your lab means ensuring efficient workflows with accurate data. In addition to practicing quality control (QC), you also have to carry out your processes in compliance with industry standards. Regulatory bodies like the Food and Drug Administration (FDA) and the Food Safety and Inspection Service (FSIS), and local agencies of countries to which you export may all have specific standards that you need to follow.
As you juggle meeting the food safety standards consistently, maintaining the same quality across your products can be daunting with mitigating consequences — from poor food quality to customers’ distrust. Audits are necessary to ensure that your lab consistently maintains compliance with these evolving regulations and standards.
How can you get your food testing lab ready for an audit with little or no hassle? Understand what audit management entails and why it is vital in food and beverage testing.
What is Audit Management
Dealing with audits in your lab means ensuring your food testing processes, equipment, and systems are compliant with the industry standards. Again, the food regulatory bodies set these standards and include checks on the quality and integrity of the data you generate in your lab. Carrying out audits frequently is beneficial to you, as the goal is to assure your customers that your test results are reliable.
Food safety is a majorly sensitive factor where a slight difference in a decimal point or a calculation error can lead to the distribution of unhealthy or unsafe products. From such a situation, your lab falls victim to adverse effects ranging from upset customers pursuing legal action to loss of revenue from refunding retailers. You could also face fines from food agencies.
Audit management helps you organize the lab workflow, ensuring that the necessary data is always audit-ready. In addition to facilitating the collaboration process of compiling audits and confirming that all stakeholders are on the same page, audit management covers internal and external audits to assess the processes in the organization in line with industry guidelines. With intelligent software, you conserve resources to arrange data for audits, effectively schedule assessments and mitigate errors.
Your lab can encounter several types of audits, whereas the regulatory body can notify you about the audit, or your processes get assessed without any prior announcement. We recommend that you schedule frequent internal audits to keep your procedures and facilities compliant with industry standards. By implementing regular internal audits, you can easily spot areas that require improvement and stay prepared for external audits.
Why are Audits Necessary in Food and Beverage Testing?
Constructive feedback is beneficial for crucial improvement in your processing facilities and business. In food and beverage testing, it can be easy to get overwhelmed with consumers’ demands, increasing the possibility of error-prone processes. However, with the help of audits from certified regulatory bodies, customers, and internal audits, you can take a step back to reassess your method and utilize different modes of improvement that can enhance your work.
Seeing audits as opportunities to optimize your processes to better results with higher standards helps reduce stress when encountering them. With adequate preparation, honesty, and attention to detail, you can extract quality learning experiences from your audits. When you take notes of the necessary corrective actions and implement them, you can increase the quality of your processes, which can generate more revenue from improved consumer satisfaction.
The Benefits of Using LIMS for Your Food Testing Lab's Audit Management
Regulatory bodies periodically update food testing and production standards to improve processes and combat food safety challenges. From complying with regulations to keeping up with the demands of business shareholders, wholesalers, and consumers, getting overwhelmed from managing everything is not far-fetched. However, you can generate more robust workflows that boost your testing efficiency and maintain compliance with an intelligent management system.
This is where a laboratory information management system (LIMS) can be valuable to manage your food and beverage testing workflows in compliance with industry standards and consumer needs.
Automated Tracking
By providing a reliable tracking system of product batches from raw materials to finished goods, a LIMS gives the necessary information that regulatory bodies need during an audit. With a single query, you can effortlessly find records such as the release of batch products, the details of the tests carried out, the individual who performed the test, and who approved the testing process. Trying to get the same level of information using paper records can take up to days or even weeks, having adverse effects on your inspection.
Detailed Reporting
A LIMS automatically labels each sample with unique barcodes, accurately tracing each sample to its batch and product. In addition to tracking, you can even tag your food products, providing information like specifications and nutritional content to your consumers. Inspectors can also access custom test reports or Certificates of Analysis (CoAs) generated by a LIMS after the approval and validation of test results.
A LIMS consists of a fully traceable system that records processes before, during, and after testing. This integral method of recording testing methods from start to finish provides transparent data that prepares your laboratory for regulatory audits.